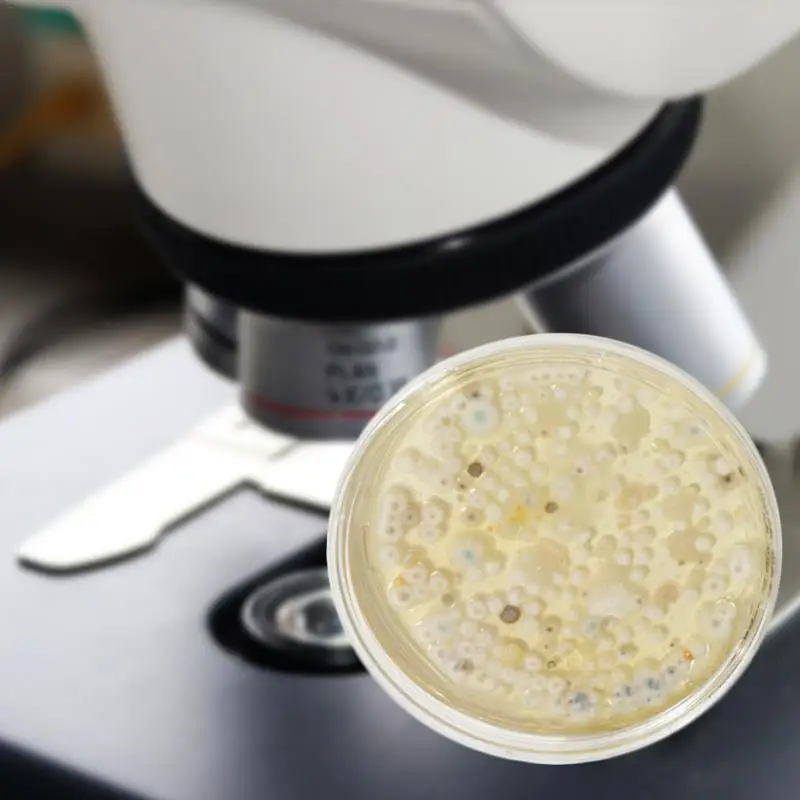

- Rumah
- Penjualan terbaik
-
semua Kategori
- semua Kategori
- Wanita Pakaian
- Pria Pakaian
- Telepon & Telekomunikasi
- Komputer & Kantor
- Elektronik konsumen
- Perhiasan & Aksesoris
- Rumah & Taman
- Bagasi & Tas
- Sepatu
- Buku & Barang Dagangan Budaya
- Sports Shoes,Clothing&Accessories
- Pakaian dalam, Kaus Kaki, Tidur & Lounge Pakaian
- Sepeda motor equipments & parts
- Lampu & Pencahayaan
- newlv1categorytest
- Olahraga & Hiburan
- Keamanan & Perlindungan
- Test category 06
- Novelty & Khusus Penggunaan
- Pernikahan & Acara
- Komponen elektronik & Supplies
- Alat
- Ibu & Anak
- Industri & Bisnis
- Aksesoris Telepon & Telekomunikasi
- Kantor & Perlengkapan Sekolah
- Mobil & Sepeda Motor
- Peralatan rumah
- Aliexpress Service Market
- Furniture
- Rambut Ekstensi & Wig
- Mainan & Hobi
- Jam tangan
- Kecantikan & Kesehatan
- Makanan
- Aksesoris pakaian
- Perbaikan rumah
- Semua Toko